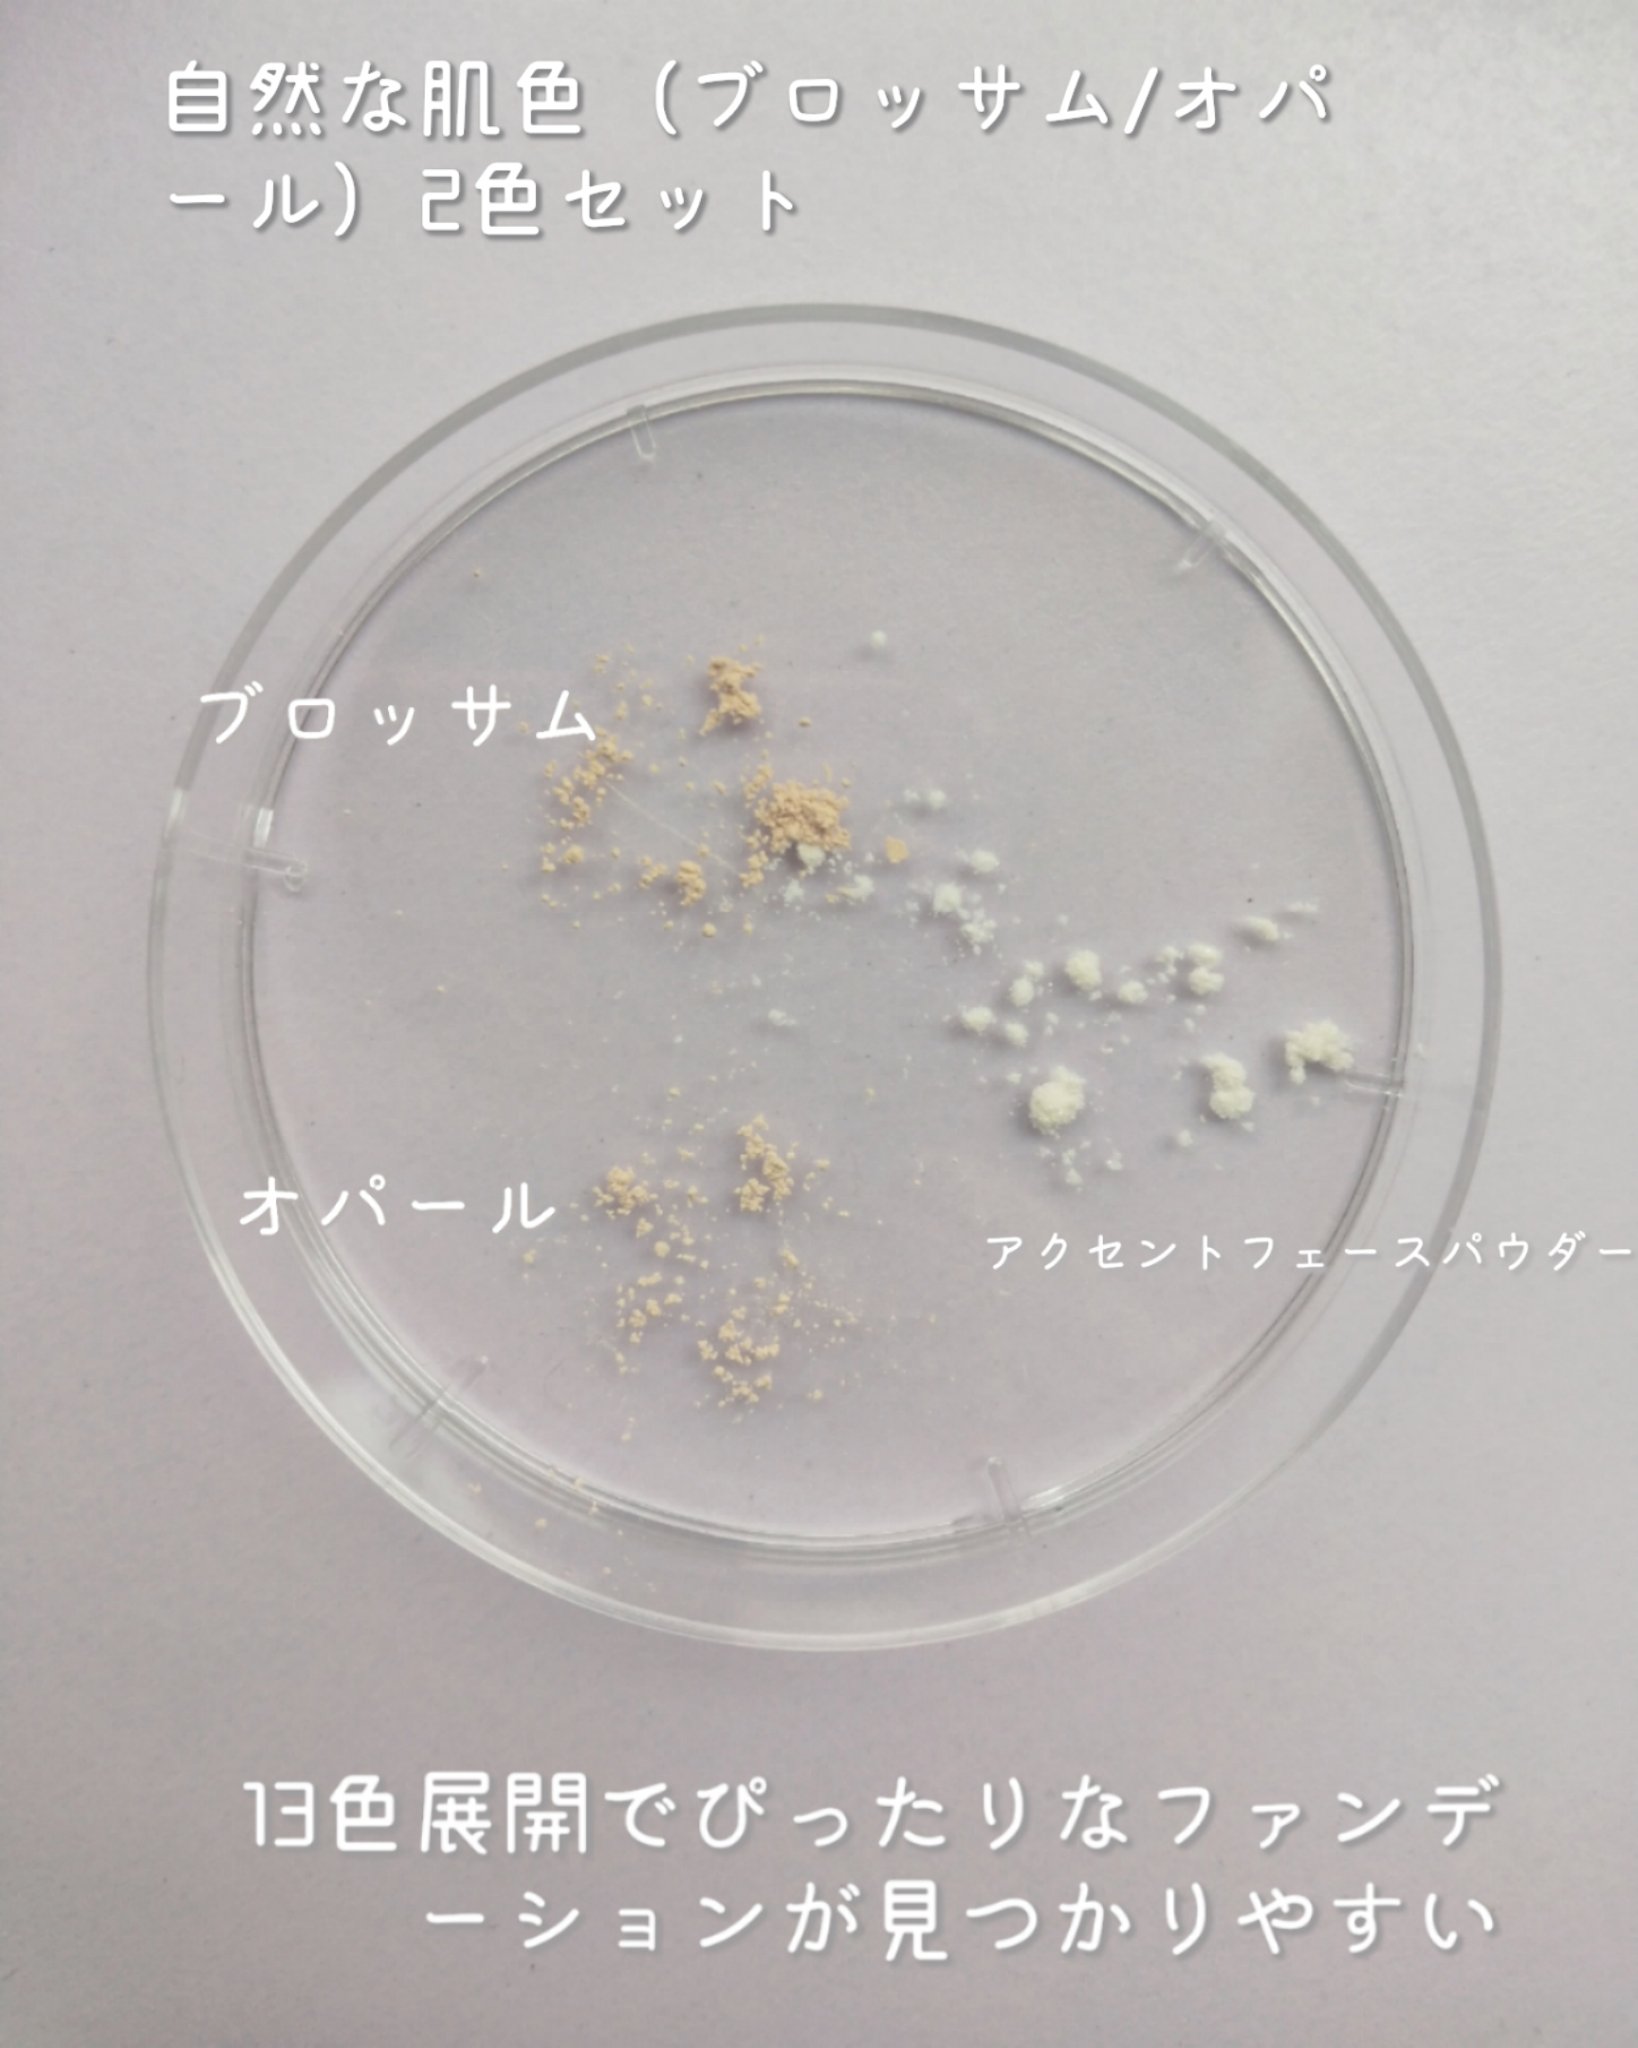

▶レイチェルワイン/ミネラルメイクアップトライアルセットレイチェルワインはこだわりの成分で肌にやさしい、国産のミネラルファンデーションです💜✅おすすめポイント・6,600円相当→1,980円(送料無料)本品ブラシが付いてくるお得なセット!🉐・...
もっと見るトライアルキットランキング
| 商品画像 | 商品情報 | 参考価格 | 評価 | ランキングIN | 特徴 | 商品リンク |
|---|---|---|---|---|---|---|
SK-II ピテラ™ ヒーロー セット | 12,650円(編集部調べ) |
| SK-IIのベストセラー3品を揃えた豪華なトライアルセット!SK-IIを試してみたいという方におすすめ。 | 詳細を見る | ||
キュレル 潤浸保湿 フェイスケアセット III とてもしっとり | 1,045円 |
| コフレ・キットランキング第22位 | ミニ サイズなので 旅行に行く時も 便利なサイズですよね。 | 詳細を見る | |
VT VT リードルS トライアル3ステップキット ペプチド | 110円 |
| コフレ・キットランキング第26位 | 詳細を見る | ||
キュレル 潤浸保湿 フェイスケアセット II しっとり | 1,045円 |
| コフレ・キットランキング第29位 | 化粧水にはとろみがあって、ちゃんと保湿してくれます!乳液も結構さっぱりしてて、軽いのにきちんと保湿してくれる✨ | 詳細を見る | |
N organic モイスチュア&バランシング トライアルキット | 1,408円 |
| コフレ・キットランキング第32位 | 肌の状態に合わせてスキンケアが出来るトライアルセット!数種類のオーガニック成分を悩み事に配合 | 詳細を見る | |
MAPUTI MAPUTI トライアルセット | 1,980円 |
| コフレ・キットランキング第31位 | 石鹸、ホワイトクリーム、美容液の 三種類のミニボトルが入っていて大満足でした😊 | 詳細を見る | |
d プログラム モイストケア セット MB | 1,100円 |
| コフレ・キットランキング第44位 | 乳液も伸びが良くて、使いやすいと思います😊 香りも無いので、香り付きが苦手な方にもオススメです🍀 | 詳細を見る | |
ミノン ミノン アミノモイスト 敏感肌・乾燥肌ライン トライアルセット | 880円(編集部調べ) |
| コフレ・キットランキング第47位 | 肌に馴染みも良く、ベタつきも少なく、良い感じです😃 | 詳細を見る | |
エトヴォス エトヴォス パーフェクトキッド | 1,980円 |
| どれもハズレがなく、 まだエトヴォスを試したことがない人は フルラインで試せるのでおすすめです! | 詳細を見る | ||
オルビス クリアフル トライアルセット L | 1,320円 |
| コフレ・キットランキング第78位 | お試しにはもちろん、旅行用にも持っていたい♥ | 詳細を見る |
Panamama【フォロバ】さんの人気クチコミ
潤い成分のユーカリエキス、抗炎症成分のアラントインを配合で肌あれ予防にも。 こちらはとてもしっとりタイプの化粧水ですが テクスチャーはさらっとしていてなじみやすく、潤いを感じながらベタつかない使用感です。 ポンプ式なので、一度に出る量がちょうど良く使いやすいです。 低刺激で安心して使えるので 肌が弱っているときはこちらを使いたいです。
もっと見る
141
5
- 2023.06.09
繊細パールがきらめくオーロラハイライトとふんわりした発色のヴェールチークのパレット🎨 コントラストカラー、隣接色が自然に馴染むグラデーションカラーの2種類から仕上がりが選べます。 ほわっとした発色と繊細なラメによるハイライト効果で、毛穴の目立たない均一できれいな肌仕上がりに🪞
もっと見る
135
11
- 2025.03.05
歯を暗く感じさせる原因だった 歯の表面の細かいキズに入り込んだ着色汚れ 「ステイン」を浮かせて落としやすくする 「無水ピロリン酸Na(清掃助剤)」に着目した歯磨き粉です。 フッ素※1 がエナメル質の修復※2 を促進し虫歯予防 口臭予防にLSS※3 配合 天然ミント配合。 マイルドなミント味で、ほんのりグレープフルーツやライチの甘い香りが爽やかです。 泡質が良くて使いやすいです。 すすいだ後は甘めのミントの後味がスッキリした使用感です。
もっと見る
135
2
- 2023.06.10
D'AlbaVeganeryダイエットゼリー4200mgバッグにすっぽりスティックタイプで手軽に摂取できおやつの感覚で気軽に摂取できる美味しいゼリーシャインマスカット風味でさっぱりと摂取できますシャーベットのように冷凍して、ひんやりと楽しむの...
もっと見る
134
2
- 2025.04.03
ザ・コラーゲンにはベーシックシリーズとEXRシリーズがあり、EXRはワンランク上のリッチラインになります♪ 独自のスーパー果実由来の美容特許成分(コケモモ+アムラ果実)※22倍量※ 低分子コラーゲン、ヒアルロン酸(2倍量※)、セラミド(2倍量※)、ビタミンCなどの美容成分を多数配合 金のキャップにピンクのボトルがラグジュアリーな雰囲気です。 味は甘さ控えめなミックスフルーツ味で 飲みやすくて美味しいです。 12kcalと低カロリーなところもありがたいです。
もっと見る
127
5
- 2023.06.10
fweeからNEWポケットシリーズ登場🪄手のひらサイズ&キーリング付きでカバンにつけてお直し用に持ち運んでもかわいいポケットシリーズ👝フィーポケットアイパレット フィーポケットチークパレット アイシャドウは実用的なカラーが揃い指だけでも綺麗に...
もっと見る
123
3
- 2025.04.06
![LIPS[リップス] - コスメのクチコミ検索アプリ](https://cdn.lipscosme.com/assets/lips_logo_full_2022-bc7b4bc9dd66035bc5696b0d16bc3d38a7be357186656c039e68cc4cf21ae675.png)

コメント